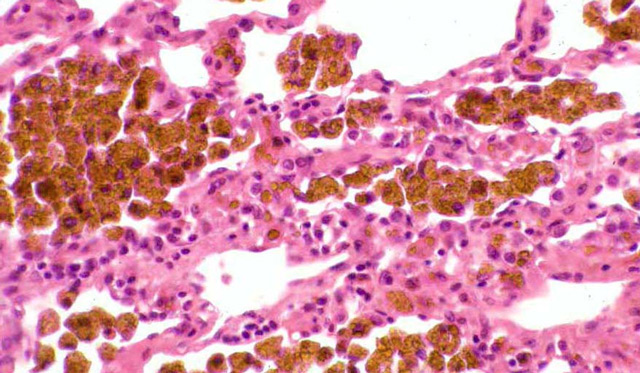

Виды гемосидероза
При гемолизе, который представляет собой разрушение эритроцитов и высвобождение гемоглобина вне сосудистой системы, возникает гемосидероз. Избыточное накопление пигмента в определённой области тела не приводит к повреждению тканей. Однако, если они уже подверглись склеротическим изменениям, это может негативно сказаться на функционировании органа.
Врачи отмечают, что гемосидероз является заболеванием, характеризующимся накоплением гемосидерина в тканях, что может привести к различным осложнениям. Основные симптомы включают усталость, слабость, боли в суставах и изменение цвета кожи, что может затруднить диагностику. Специалисты подчеркивают важность раннего выявления заболевания, так как это позволяет предотвратить серьезные последствия, такие как повреждение органов. Лечение гемосидероза обычно включает флеботомию для снижения уровня железа в организме и применение препаратов, способствующих его выведению. Врачи также рекомендуют соблюдать диету с низким содержанием железа и регулярно проходить обследования для контроля состояния пациента.

Отложения гемосидерина в тканях (идиопатический лёгочный гемосидероз)
При гемолизе, происходящем внутри сосудов, развивается общий гемосидероз. Он характеризуется значительными отложениями гемосидерина в внутренних органах. Наиболее часто страдают клетки печени и селезёнки, но могут быть затронуты и другие органы. В результате их цвет становится более тёмным из-за накопления пигмента. Обычно общий гемосидероз возникает на фоне системных заболеваний организма.
Существуют также несколько других форм гемосидероза:
- Лёгочный эссенциальный.
- Наследственный.
- Дерматологический. Эта форма включает такие заболевания, как болезнь Майокки, охряный дерматит, болезнь Гужеро-Блюма и болезнь Шамберга.
- Печёночный.
- Идиопатический.
| Симптом | Описание | Возможные причины (в контексте гемосидероза) |
|---|---|---|
| Утомляемость | Постоянное чувство усталости и слабости. | Накопление железа в органах и тканях, что приводит к повреждению клеток иснижению их функции. |
| Одышка | Затрудненное дыхание, особенно при физической нагрузке. | Накопление железа в легких (гемосидероз легких), что приводит к фиброзу и снижению легочной функции. |
| Кожный зуд | Сильный зуд кожи. | Накопление железа в коже, что может вызывать воспаление и раздражение. |
| Боль в суставах | Боль и скованность в суставах. | Отложение кристаллов железа в суставах, вызывающее воспаление (гемохроматоз). |
| Потемнение кожи | Потемнение кожи, особенно на открытых участках тела. | Накопление железа в коже (бронзовый диабет). |
| Цирроз печени | Повреждение печени, приводящее к рубцеванию и нарушению ее функции. | Накопление железа в печени, что приводит к воспалению и фиброзу. |
| Диабет | Повышенный уровень сахара в крови. | Накопление железа в поджелудочной железе, что повреждает клетки, продуцирующие инсулин. |
| Сердечная недостаточность | Неспособность сердца эффективно перекачивать кровь. | Накопление железа в сердечной мышце, что приводит к кардиомиопатии. |
| Гиперпигментация | Избыточная пигментация кожи | Отложение гемосидерина в коже |
Причины гемосидероза
На сегодняшний день причины гемосидероза остаются недостаточно изученными. Это состояние не является самостоятельным заболеванием, а представляет собой вторичное расстройство, возникающее на фоне уже существующих проблем в организме.
К группе риска по гемосидерозу относятся:
- Пациенты с заболеваниями крови и нарушениями кроветворения (например, лейкемия, гемолитическая анемия).
- Люди, страдающие инфекционными болезнями, такими как сепсис, бруцеллез, малярия и тиф.
- Лица с аутоиммунными заболеваниями и нарушениями иммунной системы.
- Люди с патологиями сосудистой стенки.
- Пациенты с сосудистыми заболеваниями, включая хроническую венозную недостаточность и гипертонию.
- Лица, испытывающие интоксикацию организма.
- Женщины с резус-конфликтом.
Гемосидероз может развиваться у тех, кто часто получает переливания крови. Также в группе риска находятся люди с наследственной предрасположенностью к этому состоянию. Вероятность гемосидероза увеличивается при наличии дерматологических заболеваний, травм и ссадин на коже, переохлаждении, приеме определенных медикаментов и избыточном поступлении железа с пищей.
Гемосидероз — это заболевание, связанное с избыточным накоплением железа в организме. Многие пациенты отмечают, что первыми симптомами являются усталость, слабость и боли в суставах. Эти проявления могут быть неочевидными, что затрудняет диагностику на ранних стадиях. Важно отметить, что некоторые люди также замечают изменения в цвете кожи, которая может приобретать бронзовый оттенок.
Лечение гемосидероза обычно включает в себя методы, направленные на снижение уровня железа. Это может быть как медикаментозная терапия, так и процедуры, такие как флеботомия, при которой из организма удаляется кровь. Важно, чтобы лечение проводилось под контролем врача, так как неправильное вмешательство может привести к серьезным осложнениям. Многие пациенты отмечают, что соблюдение диеты с низким содержанием железа также помогает в управлении заболеванием.

Симптомы гемосидероза
Симптоматика гемосидероза зависит от места поражения. Заболевание может проявиться неожиданно, но его развитие происходит постепенно.
При гемосидерозе кожи высыпания могут сохраняться на протяжении нескольких месяцев или лет. Пациенты испытывают зуд, который может быть довольно сильным. Пигментация проявляется в виде пятен с четкими границами, окрашенных в красный цвет, которые не исчезают при нажатии на кожу.
При легочном гемосидерозе у пациента возникает одышка, даже в состоянии покоя. Человек страдает от влажного кашля с выделением кровянистой мокроты. Температура тела может значительно повышаться, усиливаются симптомы дыхательной недостаточности, увеличиваются печень и селезенка, появляются признаки анемии. Спустя несколько дней может наступить облегчение, и уровень гемоглобина в организме нормализуется.
Гемосидероз лёгких
Гемосидероз легких — это заболевание с неясной причиной, характеризующееся тяжелым хроническим течением. У пациентов часто наблюдаются повторные кровоизлияния в альвеолы, что приводит к распаду эритроцитов в легочной ткани и выделению значительного количества гемосидерина. Эти процессы ухудшают способность легких выполнять свои основные функции.

Симптомы гемосидероза легких в остром периоде заболевания:
- Кашель с кровянистой мокротой.
- Бледность кожи.
- Кровоизлияния в склеры глаз.
- Хроническая усталость.
- Одышка.
- Боли в груди и суставах.
- Повышенная температура.
- Учащенное сердцебиение.
- Низкое артериальное давление.
- Увеличение селезенки и печени.
После острого периода пациент может чувствовать себя относительно хорошо и продолжать выполнять повседневные обязанности. Однако с прогрессированием заболевания рецидивы становятся более частыми, а периоды ремиссии сокращаются.
При тяжелом течении гемосидероза у больного может развиться легочное сердце, пневмония или пневмоторакс, что в некоторых случаях приводит к летальному исходу.
Во время аутопсии у ряда пациентов выявляется бурая индурация легких, которая редко диагностируется при жизни. В крови таких больных образуются аутоантитела — комплекс антител и антигенов. Это вызывает воспалительную реакцию, локализующуюся в легких, так как их ткань становится целью для аутоантител. Мелкие сосуды, пронизывающие легочную паренхиму, расширяются, из них выходят эритроциты, распадающиеся в легочной ткани, что приводит к избыточному накоплению гемосидерина.
Гемосидероз кожи
При поражении кожи возникают высыпания тёмного оттенка. Эти образования появляются из-за накопления пигмента в клетках кожи на фоне разрушения капилляров, пронизывающих сосочковый слой дермы.
Цвет и размеры высыпаний могут варьироваться. Новые высыпания имеют яркий, красный цвет, тогда как старые, существующие длительное время, становятся бледнее, приобретая коричневый или желтоватый оттенок. Пятна могут располагаться на руках, ногах, кистях и предплечьях, достигая диаметра до 3 см. Также на коже могут образовываться узелки, бляшки, папулы и петехии. Пациенты часто жалуются на зуд и жжение в поражённых участках.
В капиллярах, пронизывающих дерму, наблюдается повышение давления, что приводит к просачиванию плазмы с эритроцитами через стенки сосудов. В результате их разрушения накапливается гемосидерин. При клиническом анализе крови может быть выявлено снижение уровня тромбоцитов и наличие анемии.
Наиболее часто кожная форма гемосидероза проявляется в виде ортостатической, экземоподобной и зудящей пурпуры, а также болезни Майорки.
Болезнь Шамберга
Болезнь Шамберга — распространенное аутоиммунное заболевание с хроническим течением. На коже пациента появляются ярко-красные высыпания, напоминающие следы от инъекций. В стенках сосудов накапливаются иммунные комплексы, что приводит к аутоиммунному воспалению в глубоких слоях дермы. Это вызывает образование мелких кровоизлияний на коже. С увеличением количества гемосидерина в сосочковом слое кожи пятна становятся больше и приобретают коричневый оттенок. В дальнейшем они могут сливаться, образуя крупные бляшки с ярко-красной каймой.
С прогрессированием болезни бляшки объединяются и могут атрофироваться, однако общее состояние пациента остается стабильным.
Дерматологический гемосидероз хорошо поддается терапии, что отличает его от гемосидероза в других областях. Восстановление пациентов происходит достаточно быстро.
Гемосидероз внутренних органов
При выраженном внутрисосудистом гемолизе эритроцитов у пациента может развиться генерализованный или системный гемосидероз. Это состояние негативно сказывается на функционировании внутренних органов и отражается на общем самочувствии человека.
Гемосидероз печени характеризуется накоплением пигмента в гепатоцитах. Это заболевание может быть как самостоятельной патологией, так и следствием других нарушений в организме. Часто установить точную причину гемосидероза не удаётся. В результате увеличивается размер печени, что становится заметным даже при легком нажатии на область её расположения. С прогрессированием болезни в брюшной полости накапливается асцитическая жидкость, повышается артериальное давление, кожа приобретает желтоватый оттенок, увеличивается селезёнка, а на руках, подмышках и лице появляются участки пигментации. При отсутствии лечения у пациента может развиться ацидоз, что приведёт к коме.
Гемосидероз почек проявляется образованием коричневых гранул на их поверхности. Заболевание может протекать в виде нефрита или нефроза. В моче выявляется белок, а уровень липидов в крови повышается. Пациенты часто отмечают отёки на нижних конечностях, болезненные ощущения в поясничной области, потерю аппетита и диспепсические расстройства. Без адекватного и своевременного лечения может развиться почечная недостаточность, что нередко приводит к летальному исходу.
Гемосидероз печени (слева) и почек (справа):
Кроме того, накопление гемосидерина может происходить в головном мозге, селезёнке и других внутренних органах. Все эти состояния связаны с серьёзными нарушениями в работе поражённых систем и часто заканчиваются летальным исходом.
Гемосидероз системного характера представляет собой заболевание, которое несёт угрозу для жизни пациента.
Диагностика гемосидероза
Для точного определения диагноза недостаточно стандартного осмотра пациента.
После осмотра необходимо назначить следующие исследования:
- Анализ крови на общий состав с определением уровня сывороточного железа и способности крови связывать железо.
- Биопсия тканей органа с последующим гистологическим анализом.
- Десфераловая проба, которая позволяет выявить гемосидерин в моче. Для этого пациенту вводят инъекцию препарата Десферал внутримышечно.
- Микроскопическое исследование кожи при наличии высыпаний.
Дополнительные методы исследования включают:
- Рентгенологическое обследование.
- Компьютерную томографию и сцинтиграфию.
- Бронхоскопию.
- Спирометрию.
- Микроскопическое изучение мокроты и её бактериологический посев.
Лечение гемосидероза
Лечение гемосидероза требует соблюдения ряда рекомендаций:
- Придерживайтесь диеты, исключив алкоголь. Уберите из рациона продукты, способные вызвать аллергические реакции.
- Избегайте переохлаждения, травм, перегрева, а также умственного и физического перенапряжения.
- Все заболевания должны быть своевременно диагностированы и пролечены.
- Устраните хронические инфекции.
- Откажитесь от косметических средств, которые могут вызвать аллергию.
- Исключите все вредные привычки.
Медикаментозная терапия включает использование следующих препаратов:
- Приём и местное применение гормональных стероидов: Преднизолон, Бетаметазон и Дексаметазон.
- Препараты для снижения воспалительных процессов: Индометацин и Ибупрофен.
- Дезагреганты: Аспирин и Кардиомагнил.
- Иммуносупрессивные средства: Азатиоприн и Циклофосфан.
- Ангиопротекторы: Диосмин и Гесперидин.
- Ноотропные препараты: Пирацетам, Винпоцетин и Максидол.
- Противоаллергические средства: Супрастин, Тавегил и Диазолин.
- Витамины и минералы: витамин С, рутин и кальций.
Кроме того, пациентам могут быть назначены препараты железа, средства для остановки кровотечений и бронхолитики. Возможно проведение оксигенотерапии. Также больных направляют на гемосорбцию, криопреципитацию, криотерапию и плазмаферез. В некоторых случаях может потребоваться переливание крови или удаление селезёнки.
Народная медицина предлагает настой коры орешника и горной арники, а также отвар толстолистного бадана.
Профилактика гемосидероза
Гемосидероз — это заболевание, которое может часто обостряться. При адекватном лечении вероятность рецидивов снижается. Однако для этого необходимо соблюдать профилактические меры, такие как сбалансированное питание, лечение в специализированных санаториях и активный образ жизни.
Чтобы предотвратить развитие гемосидероза, рекомендуется следовать следующим советам:
- Избегать самолечения инфекционных заболеваний и своевременно обращаться к врачу.
- Заботиться о здоровье сосудов.
- Контролировать артериальное давление, следить за весом и уровнем холестерина.
- Снижать риски интоксикации организма.
Вопрос-ответ
Наиболее характерный симптом гемосидероза?
Наиболее характерный симптом гемосидероза — это накопление железа в тканях, что может проявляться в виде изменения цвета кожи (потемнение), а также в нарушениях функции органов, таких как печень, сердце и поджелудочная железа.
Каковы симптомы отложения железа в коже?
Гемохроматоз — это преимущественно наследственное заболевание с накоплением железа и отложением его в тканях. Болезнь называется бронзовым диабетом из-за отложения в коже железосодержащего пигмента гемосидерина.
Советы
СОВЕТ №1
Обратите внимание на симптомы. Гемосидероз может проявляться различными признаками, такими как усталость, боли в суставах и изменения цвета кожи. Если вы заметили у себя подобные симптомы, не откладывайте визит к врачу.
СОВЕТ №2
Регулярно проходите медицинские обследования. Если у вас есть предрасположенность к заболеваниям, связанным с накоплением железа, такие как гемохроматоз, важно регулярно проверять уровень железа в крови и следить за состоянием здоровья.
СОВЕТ №3
Соблюдайте диету с низким содержанием железа. Если у вас уже диагностирован гемосидероз, стоит ограничить потребление продуктов, богатых железом, таких как красное мясо и печень, а также избегать витаминов с добавлением железа.
СОВЕТ №4
Следуйте рекомендациям врача по лечению. Лечение гемосидероза может включать флеботомию (удаление крови) или применение препаратов, снижающих уровень железа. Важно строго придерживаться назначений врача для предотвращения осложнений.